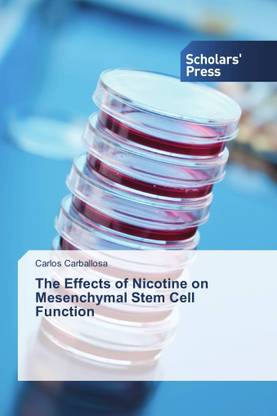
The Effects of Nicotine on Mesenchymal Stem Cell Function

The Effects of Nicotine on Mesenchymal Stem Cell Function (Paperback, Carlos Carballosa)
Price: Not Available
Currently Unavailable
Highlights
- Binding: Paperback
- Publisher: Scholars' Press
- ISBN: 9783659839580
- Pages: 52
Be the first to ask about this product
Safe and Secure Payments.Easy returns.100% Authentic products.
Back to top
